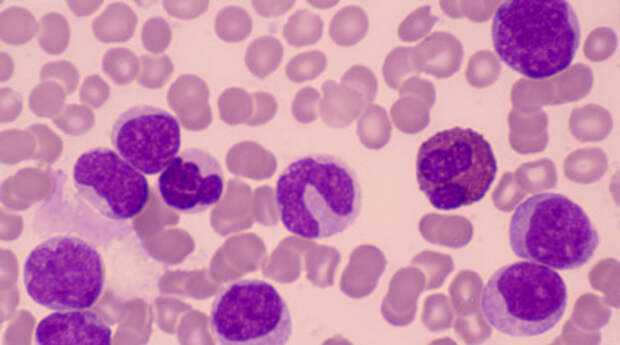

- Gettyimages.ru
- © FatCamera
— В Nature вышла научная статья, в которой авторы представили новый метод диагностики лейкемии. Учёные выяснили, как можно определить и классифицировать заболевание по изменению эпигенетических меток на ДНК. О чём идёт речь в данном случае и применяется ли подобный метод диагностики в клинической практике?
— В данной работе говорится об эпигенетическом метилировании — это небольшие химические метки на ДНК, которые помогают клетке включать или выключать определённые гены. Набор этих меток создаёт свой индивидуальный код для каждого типа опухоли. В статье описывается, как с помощью такого подхода можно классифицировать острые лейкозы.
Для считывания меток применяется метод нанопорового секвенирования, который позволяет получить результат в течение нескольких часов. Пока этот способ диагностики находится на стадии научных разработок. Полагаю, он требует специального оборудования и дополнительных исследований, чтобы подтвердить его точность и надёжность в реальной клинической практике.
— Расскажите, пожалуйста, подробнее о лейкемии. Правда ли, что это самый опасный вид рака?
— Лейкемия — это не одно заболевание, а целая группа злокачественных болезней крови и костного мозга. Существует несколько видов лейкозов, каждый из которых отличается по скорости развития, типу поражённых клеток и прогнозу. Бывают острые и хронические формы.
 «Играет ключевую роль в защите организма от рака»: биолог — о гибели клеток и будущем клеточных технологий
«Играет ключевую роль в защите организма от рака»: биолог — о гибели клеток и будущем клеточных технологий Лейкозы делят на миелоидные и лимфоидные. В первом случае костный мозг начинает вырабатывать большое количество незрелых миелоидных клеток — в норме это клетки-предшественники клеток крови. Но оказавшись в кровотоке с большим избытком, они просто вытесняют зрелые и здоровые клетки. Во втором — избыточно формируются незрелые лимфоциты, что нарушает процесс кроветворения.
У разных видов заболевания — разная биология, подходы к лечению и прогноз. Именно поэтому говорить, что лейкемия — «самый опасный рак», некорректно. Например, острый лимфобластный лейкоз у детей при современных схемах терапии часто хорошо поддаётся лечению. А хронический лимфолейкоз у взрослых может протекать медленно и даже не требовать срочного лечения.

- Gettyimages.ru
- © Roger Sutcliffe
— Какие симптомы могут указывать на лейкемию? Есть ли признаки, которые человек может не сразу связать с онкологией крови?
— Поскольку при лейкозах раковые клетки вытесняют нормальные, признаки заболевания напрямую связаны с дефицитом здоровых клеток крови. При снижении эритроцитов может возникать бледность, слабость, одышка и учащённое сердцебиение.
Если нарушена выработка тромбоцитов, появляются синяки без причины, кровоточивость дёсен, частые носовые кровотечения и обильные менструации у женщин.
При поражении лейкоцитов снижается иммунитет, и человек начинает чаще болеть, инфекции протекают тяжелее обычного.
Существуют и менее очевидные симптомы, которые можно не сразу связать с заболеванием крови. Это так называемая опухолевая интоксикация: длительная температура около 37 градусов без видимой причины, ночная потливость (настолько выраженная, что приходится менять подушку или наволочку), резкая потеря веса без диеты и приёма каких-то препаратов, а также усталость, которая не проходит даже после отдыха.
Кстати, часто хронические формы лейкемии могут не сопровождаться никакими симптомами вовсе и выявляются случайно — при сдаче общего анализа крови.
— При каких симптомах следует немедленно обратиться к врачу?
— Нельзя медлить при появлении выраженного кровотечения, внезапных синяков, высокой температуры на фоне сильной слабости или стремительного увеличения лимфоузлов на шее, в подмышках или паху. В таких случаях необходимо обратиться к специалисту в тот же день, когда обнаружили признаки. Сегодня система диагностики выстроена таким образом, что при наличии тревожных симптомов терапевт направит пациента к гематологу для детального обследования.

- Сгенерировано с помощью ИИ
— Какие ещё новые методы диагностики лейкемии применяются сегодня врачами?
— Одна из ключевых технологий, которую активно применяют в онкогематологии, — это исследование ДНК клеток с помощью высокопроизводительного секвенирования (NGS). Такой метод позволяет за один тест выявить мутации в клетках крови, которые указывают на онкологию, а также сразу определить точный подтип заболевания, оценить риски и подобрать таргетные препараты.
— Какова ситуация с лечением лейкемии на данный момент? Стало ли оно более эффективным? Какие методы и технологии появились?
— За последние годы подходы к лечению лейкемии сильно продвинулись. Заболевание, которое ещё недавно считалось смертельным, сегодня во многих случаях стало контролируемым, а иногда — полностью излечимым.
«Избирательное уничтожение»: российские учёные нашли способ разрушать раковые клетки изнутри
«Избирательное уничтожение»: российские учёные нашли способ разрушать раковые клетки изнутри Особенно заметен прогресс при хронических формах. Так, при хроническом лимфолейкозе применяются новые препараты, такие как ингибиторы тирозинкиназы Брутона (фермент, играющий роль в созревании клеток крови. — RT.). Они способны давать эффект даже в случае пациентов, которым не помогали другие типы терапии. При регулярном приёме такие препараты помогают пациентам прожить долго, наравне со здоровыми людьми.
Хронический миелоидный лейкоз тоже стал контролируемым: современные препараты позволяют достичь глубокой ремиссии. А при острых формах лейкоза, особенно в случае рецидива, применяются инновационные иммунные препараты, такие как биспецифические антитела, а также CAR-T-клеточная терапия, в ходе которой иммунные клетки пациента обучаются бороться с опухолью.
Такие методы уже применяются и в России, в том числе в детском и взрослом федеральных центрах гематологии.
Благодаря новым методам диагностики, лечение можно подбирать индивидуально, учитывая особенности конкретного пациента.

- Gettyimages.ru
- © Morsa Images
— Что влияет на прогноз и можно ли говорить о полном выздоровлении или длительной ремиссии?
— Прогноз зависит от вида лейкемии, возраста пациента и сопутствующих болезней. На такой вопрос я обычно отвечаю пациентам, что у нас могут быть как считанные дни, так и годы. Конкретные шансы достичь ремиссии мы всегда обсуждаем индивидуально после уточнения подтипа заболевания, генетических особенностей и общего состояния пациента. Зачастую не ставится цель полного излечения. Например, в случае с пожилыми пациентами нередко задача заключается лишь том, чтобы перевести болезнь в контролируемое состояние, как при диабете или гипертонии.
— Известно, что разные привычки и условия могут быть факторами риска для некоторых видов онкологии. Например, курение способно повысить вероятность развития рака лёгких. Есть ли такие же факторы для лейкемии и можно ли снизить риск её развития с изменением образа жизни?
— В отличие от, скажем, рака лёгких, у лейкозов нет такой выраженной связи с образом жизни. Полностью предотвратить развитие лейкемии, к сожалению, невозможно.
Но всё же для профилактики я рекомендую проходить регулярные медосмотры и укреплять иммунитет в целом.
Также полезна и физическая активность. Она снижает риск ряда опухолей, помогает держать в норме вес, уровень глюкозы и артериальное давление. Всё это косвенно снижает и онкориски, в том числе возможные нарушения в кроветворении.
Свежие комментарии